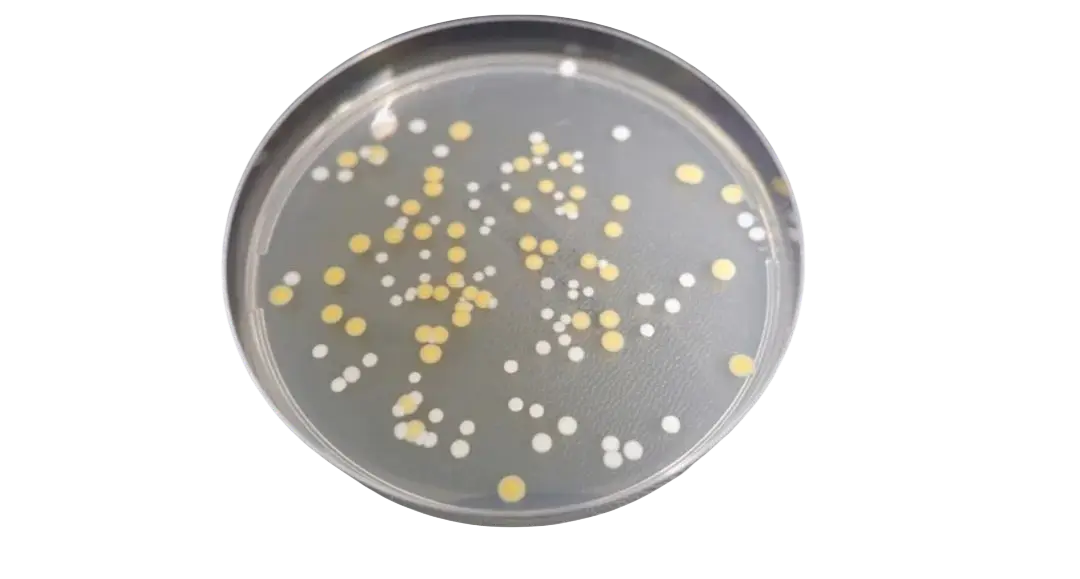
培养皿 - 表皮葡萄球菌和金黄色葡萄球菌
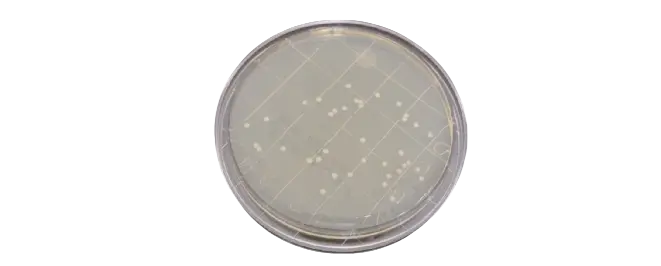
培养皿 - 金黄色葡萄球菌 TSA L + T 24 小时
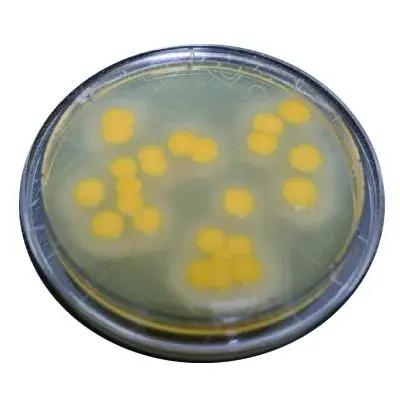
培养皿 - 金黄色葡萄球菌 TSA L + T 5 天
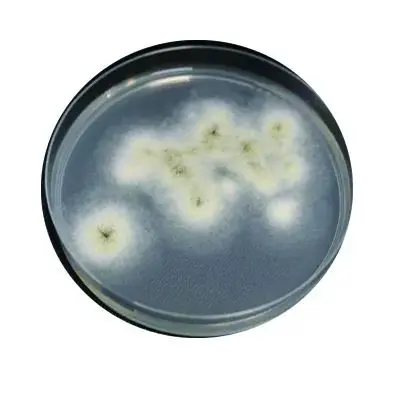
图 3b - 培养皿 - 曲霉菌4天
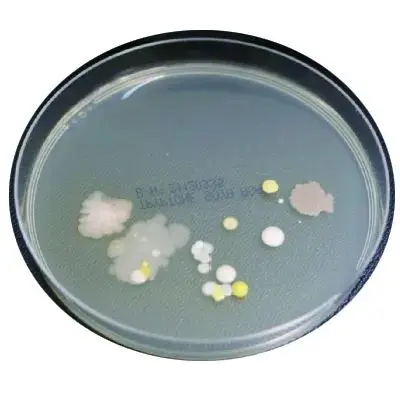
图 4-培养皿-不规则簇状生长

培养沉降皿:了解生长模式以及何时出现问题
发布时间:2025-05-16 浏览次数:608
转载自Cleanroom Technology(2025.01.02发布)。
Incubating settle plates: Understanding growth patterns and when things are going wrong
培养沉降皿:了解生长模式以及何时出现问题
Published: 2-Jan-2025
Steven Brimble from Cherwell Laboratories discusses why it is important to your environmental monitoring regime to understand growth characteristics of common cleanroom contaminants and how morphology shifts over time on various media.
Cherwell Laboratories 的 Steven Brimble 讨论了为什么了解常见洁净室污染物的生长特性以及形态在各种培养基上随时间的变化对于环境监测制度很重要。
Environmental monitoring (EM) is essential for ensuring that cleanroom environments maintain the highest standards of cleanliness and are suitable for manufacturing sensitive products, especially in industries such as pharmaceuticals, biotechnology, and electronics.
环境监测 (EM) 对于确保洁净室环境保持最高清洁度标准并适合制造敏感产品至关重要,尤其是在制药、生物技术和电子等行业。
Effective monitoring not only ensures product quality, but also serves as a critical data source when deviations or non-conformances occur.
有效的监控不仅可以确保产品质量,而且在出现偏差或不合格时还可以作为关键的数据来源。
A robust EM programme should provide insights into the types of microorganisms present in a cleanroom, their behaviour, and how these factors impact operations, such as the selection of disinfectants. So, the ability to identify viable bacteria and mould is crucial for preventing contamination and ensuring the effectiveness of cleaning regimes.
完善的 EM 程序应提供有关洁净室中微生物类型、其行为以及这些因素如何影响操作(例如消毒剂的选择)的见解。因此,识别活细菌和霉菌的能力对于防止污染和确保清洁方案的有效性至关重要。
Both species showing similar growth patterns at five days, but with sufficient characteristic differences for accurate identification
两种物种在五天时都表现出相似的生长模式,但具有足够的特征差异以实现准确识别
This article delves into the practicalities of EM, focusing on the growth patterns of different organisms, culture media types, and the impact of incubation conditions. We'll explore the growth characteristics of common cleanroom contaminants and discuss how morphology shifts over time on various media.
本文深入探讨了 EM 的实用性,重点关注不同生物的生长模式、培养基类型以及培养条件的影响。我们将探讨常见洁净室污染物的生长特性,并讨论形态在各种培养基上如何随时间变化。
Understanding these principles is essential for optimising microbial recovery rates and ensuring that cleanroom environments remain under control.
了解这些原则对于优化微生物回收率和确保洁净室环境得到控制至关重要。
The role of environmental monitoring in cleanrooms
环境监测在洁净室中的作用
Environmental monitoring in cleanrooms primarily focuses on viable bacteria and fungi, ensuring that the microbial load remains within acceptable limits
洁净室的环境监测主要关注活的细菌和真菌,确保微生物负荷保持在可接受的限度内
The data collected play a pivotal role in releasing products, as cleanrooms must remain free of contamination in order to avoid product quality being compromised.
收集的数据在产品放行过程中起着关键作用,因为洁净室必须保持无污染,以避免产品质量受到影响。
When deviations or non-conformances arise, EM data serve as reference points, allowing microbiologists and quality control (QC) staff to investigate the source of contamination, the effectiveness of disinfectants, and the overall hygiene of the environment.
当出现偏差或不符合情况时,EM数据可作为参考点,让微生物学家和质量控制 (QC) 人员调查污染源、消毒剂的有效性以及环境的整体卫生状况。
Dual incubation regimes are often implemented to reduce the need for additional EM plates
通常会实施双重培养方法,以减少对额外EM皿的需求
Each of the methods used in cleanroom monitoring – the collection of air samples, surface swabs, and settling plates – helps build a comprehensive profile of the cleanroom environment, by highlighting trends and identifying potential sources of contamination.
洁净室监测中使用的每一种方法-收集空气样本、表面拭子擦拭、沉降皿——都有助于通过强调趋势和识别潜在污染源来建立洁净室环境的全面概况。
These microbial profiles are often specific to an individual cleanroom, taking into account factors such as the activities carried out, the materials present, and even the operators working within the space. It's therefore critical to regularly review and update monitoring strategies in order to reflect any changes in cleanroom operations or layout.
这些微生物概况通常特定于单个洁净室,考虑到所进行的活动、存在的物料,甚至在空间内工作的操作员等因素。因此,定期审查和更新监测策略以反映洁净室操作或布局的任何变化至关重要。
Understanding the types of organisms isolated through EM is key. For example, common contaminants such as Staphylococcus aureus, Staphylococcus epidermidis, and Aspergillus species are often encountered. By studying the growth patterns of such organisms and how they change based on incubation conditions and media type, QC staff can make more informed decisions regarding contamination control and root cause analysis.
了解通过 EM 分离的生物类型是关键。例如,经常遇到金黄色葡萄球菌、表皮葡萄球菌和曲霉菌等常见污染物。通过研究这些生物的生长模式以及它们如何根据培养条件和培养基类型发生变化,QC人员可以就污染控制和根本原因分析做出更明智的决策。
Morphology and incubation times: A case study
形态和培养时间:案例研究
Let’s take Staphylococcus epidermidis, a Gram-positive cocci, as an example.
我们以革兰氏阳性球菌表皮葡萄球菌为例。
Following incubation on tryptic soy agar (TSA) at 24 hours incubation at 30-35°C, its colonies appear small, smooth, and regular in shape. This can make it challenging to distinguish between other bacteria that might be present on the plate. However, after an additional 24 hours of incubation, the colonies become more distinct, exhibiting typical characteristics, such as larger size and classic morphology (Figure 1).
在 30-35°C 的温度下在胰蛋白酶大豆琼脂 (TSA) 上培养24小时后,其菌落看起来小而光滑,形状规则。这使得区分可能存在于平皿上的其他细菌变得困难。然而,再次培养24小时后,菌落变得更加明显,表现出典型特征,例如尺寸更大和形态典型(图 1)。
Figure 1: Incubating plates - staph epidermidis and aureus
图 1:培养皿 - 表皮葡萄球菌和金黄色葡萄球菌
Therefore, incubation time can significantly influence the appearance of colonies. Another example is Staphylococcus epidermidis and Staphylococcus aureus – though belonging to the same genus – can be distinguished by their pigmentation after 48 hours of incubation at 30–35°C.
因此,培养时间对菌落外观有显著影响。另一个例子是表皮葡萄球菌和金黄色葡萄球菌——虽然属于同一属——但在 30–35°C 下培养 48 小时后,可以通过它们的色素沉着来区分。
Over time, this visual differentiation becomes more apparent, with both species showing similar growth patterns at five days, but with sufficient characteristic differences for accurate identification. The morphology is a crucial part of microbial identification, whether this is used in conjunction with traditional phenotypic tests or alongside identification platforms.
随着时间的推移,这种视觉差异变得更加明显,两种物种在五天时表现出相似的生长模式,但具有足够的特征差异以实现准确识别。形态学是微生物鉴定的关键部分,无论是与传统表型测试结合使用还是与鉴定平台一起使用。
Moulds spreading across plates will make the ability to record the number and identification of bacteria more challenging
霉菌遍布培养皿,使记录细菌数量和鉴定细菌变得更加困难
This demonstrates how crucial incubation time and temperature is to effective bacterial identification. It must be noted that if plates are needing to be inspected frequently due to an investigation, reading plates at 24 hours might lead to misidentification or inaccurate results. Knowing those organisms which present better at greater than 48 hours provides clearer and more accurate results – a practice that QC staff should understand as part of their monitoring protocols.
这表明培养时间和温度对于有效细菌鉴定至关重要。必须注意的是,如果由于调查需要频繁检查培养皿,则读取 24 小时培养皿可能会导致错误鉴定或不准确的结果。了解哪些微生物在48小时以上表现更好,可以提供更清晰、更准确的结果——这是 QC 人员应将其作为监测方案的一部分来理解的做法。
The impact of media on morphology
培养基对形态的影响
In cleanrooms, the choice of media plays a critical role in the recovery of contaminants. TSA is a commonly-used medium, but when additional components such as Lecithin and Tween are introduced, they can impact on the morphology of recovered bacteria.
在洁净室中,培养基的选择对于污染物的回收起着至关重要的作用。TSA 是一种常用的培养基,但当加入卵磷脂和吐温等其他成分时,它们会影响回收细菌的形态。
For instance, Staphylococcus aureus grown on TSA with lecithin and Tween at 24 and 48 hours exhibits similar morphology to TSA without additions. However, by day five, the media additives can cause morphological changes, which can complicate phenotypic identification (Figure 2). This underscores the importance of understanding the impact of media on microbial growth.
例如,在含有卵磷脂和吐温的TSA上培养 24 小时和 48 小时的金黄色葡萄球菌,其形态与未添加任何添加剂的TSA相似。然而,到第五天,培养基添加剂会引起形态变化,从而使表型鉴定变得复杂(图2)。这强调了了解培养基对微生物生长的影响的重要性。
Figure 2a - Incubating plates - staph aureus TSA L + T 24hour
图 2a - 培养皿 - 金黄色葡萄球菌 TSA L + T 24 小时
Figure 2b Incubating plates - staph aureus TSA L + T 5 days
图 2b 培养皿 - 金黄色葡萄球菌 TSA L + T 5 天
Dual incubation regimes and their effects
双重培养方法及其影响
Dual incubation regimes are often implemented to reduce the need for additional EM plates. One set of plates is first placed at a temperature of 20-25°C and following five day incubation, these plates are read and moved to a 30-35°C incubation for 48 hours, or variations of this. This practice ensures the detection of both environmental bacteria and fungi. This may play a role in influencing colony morphology. Again, QC staff should understand how incubation conditions affect the organisms they are monitoring. This knowledge equips them to make better decisions, when choosing media and incubation protocols, to optimise the recovery of viable microorganisms.
通常会实施双重培养方案,以减少对额外EM皿的需求。首先将一组培养皿置于20-25°C的温度下,培养5天后,读取这些培养皿并移至30-35°C的培养箱中培养48小时,或以此为基准进行变化。这种做法可确保同时检测环境细菌和真菌。这可能对菌落形态产生影响。同样,QC人员应了解培养条件如何影响他们所监测的生物。这些知识使他们能够在选择培养基和培养方案时做出更好的决策,以优化活性微生物的回收率。
Fungal growth will present differently on TSA and SDA at 20-25°C and the ability to see colonies can be more challenging on TSA.
在20-25°C下,真菌生长在TSA和SDA上呈现不同情况,并且在TSA上观察菌落更困难。
Effective monitoring not only ensures product quality, but also serves as a critical data source when deviations or non-conformances occur
有效的监控不仅可以确保产品质量,而且在出现偏差或不合格时还可以作为关键的数据来源
The length of incubation time is important to ensure the visibility of all viable fungal organisms. A risk that may pose a challenge when fungi are present is more rapid growth when TSA plates are moved to the 30-35°C incubation.
培养时间的长短对于确保所有活体真菌生物的可见性非常重要。当真菌存在时,可能带来挑战的风险是,当 TSA皿移至30-35°C培养时,真菌生长速度会更快。
Moulds spreading across plates will make the ability to record the number of bacteria on the plate, along with the identification of these, more challenging. This challenge isn’t restricted to plates exposed to dual incubation, fungal growth can be rapid and present the same challenge on TSA when single incubation is used, where plates are incubated at 30-35°C.
霉菌在培养皿中蔓延,使得记录培养皿中细菌数量以及识别这些细菌的能力更加困难。这种挑战不仅限于暴露于双重培养的培养皿,真菌生长速度很快;当使用单次培养时,在30-35°C下培养培养培养皿,TSA也面临同样的挑战。
Monitoring mould growth in cleanrooms
监测洁净室中的霉菌生长
Mould contamination is a significant concern in cleanroom environments. When these are present on EM plates this can impact on the ability to read the plates effectively.
霉菌污染是洁净室环境中的一大问题。当EM皿上出现霉菌时,会影响有效读取皿的能力。
For example, when plates are incubated for 48 hours, Aspergillus may occupy only a portion of the agar plate, but by day five, its growth can cover the entire surface; this makes it almost impossible to identify any bacterial growth that might also be present (Figure 3).
例如,当培养皿培养 48 小时后,曲霉菌可能仅占据琼脂皿的一部分,但到第五天,它的生长就可以覆盖整个表面;这使得几乎不可能识别可能存在的任何的细菌生长(图 3)。

Figure 3a -Incubating plates - Aspergillus
图 3a -培养皿 - 曲霉菌
Figure 3b - Incubating plates - Aspergillus 4 days
图 3b - 培养皿 - 曲霉菌4天
As with bacteria, the choice of media can influence mould morphology. On TSA with lecithin and Tween, Aspergillus exhibits even more rapid growth than on standard TSA, quickly covering the plate and potentially masking the presence of other organisms. It's therefore crucial to evaluate environmental plates regularly during incubation to avoid missing critical contamination events. Another important consideration is the environmental conditions that promote mould growth.
与细菌一样,培养基的选择会影响霉菌的形态。在含有卵磷脂和吐温的TSA上,曲霉菌的生长速度比在标准 TSA上更快,迅速覆盖培养皿并可能掩盖其他生物的存在。因此,在培养期间定期评估环境培养皿至关重要,以避免错过关键的污染事件。另一个重要的考虑因素是促进霉菌生长的环境条件。
A robust EM programme should provide insights into the types of microorganisms present in a cleanroom
强大的环境监测程序应能洞悉洁净室中存在的微生物类型
Cleanrooms must be monitored for humidity and temperature, both of which can influence fungal contamination. If humidity levels are too high, mould growth can become uncontrollable, even with stringent cleaning and disinfection protocols. Monitoring and controlling these environmental parameters are essential to keeping mould contamination under control.
必须监测洁净室的湿度和温度,这两者都会影响真菌污染。如果湿度过高,即使采用严格的清洁和消毒规程,霉菌的生长也难以控制。监测和控制这些环境参数对于控制霉菌污染至关重要。
Recognising atypical growth patterns
识别非典型生长模式
QC staff must also be able to recognise atypical growth patterns that may result from accidents or deviations during EM.
QC人员还必须能够识别由于 EM 期间的事故或偏差而导致的非典型生长模式。
For example, plates that have been inadvertently dropped or touched by operators will exhibit unusual growth patterns, and present organisms that may have not been witnessed before. Recognising these outliers is important for correctly interpreting and trending EM data to enable risk to product to be correctly evaluated.
例如,被操作员无意中掉落或触碰的盘子会呈现出不寻常的生长模式,并出现以前可能从未见过的生物。识别这些异常值对于正确解释和趋势分析 EM 数据非常重要,这样才能正确评估产品风险。
For instance, a plate contaminated by accidental contact may show irregular, clustered growth that is unlike the smooth, even distribution typical of cleanroom contaminants (Figure 4). These insights are valuable during investigations of out-of-trend results and help ensure that corrective actions are targeted and effective.
例如,一块因意外接触而受到污染的皿可能会出现不规则的聚集增长,这与洁净室污染物典型的平滑均匀分布不同(图 4)。这些见解在调查超出趋势的结果时很有价值,有助于确保纠正措施有针对性和有效性。
Figure 4 - Incubating plates - irreg clustered growth
图 4-培养皿-不规则簇状生长
By understanding the typical growth patterns expected from environmental isolates, microbiologists can more readily identify when something is out of trend, and gain assurance nothing has been missed.
通过了解环境分离物的典型生长模式,微生物学家可以更容易地识别出何时出现趋势以外的情况,并确保没有遗漏任何内容。
The choice of media is important, along with the incubation time and temperature. This is to ensure that when a plate presents no growth, this is a true representation of no environmental risk to product and not a result of a false negative due to the environment which the organism requires to grow being compromised.
培养基的选择以及培养时间和温度都很重要。这是为了确保当培养皿中没有细菌生长时,这真正表明产品没有环境风险,而不是由于生物生长所需的环境受到损害而导致的假阴性结果。
Optimised environmental monitoring
优化环境监测
Effective EM is fundamental to maintaining cleanroom control and ensuring product quality.
有效的 EM 对于维持洁净室控制和确保产品质量至关重要。
The ability to understand how colony morphology changes over time, under different incubation conditions, and on various media types is crucial for identifying contaminants and preventing contamination. QC staff must be equipped with the knowledge and skills to interpret EM data accurately, considering factors such as incubation time, media composition, and the potential for dual incubation regimes to affect microbial recovery.
了解菌落形态在不同培养条件下以及在各种培养基类型下随时间变化的能力对于识别污染物和防止污染至关重要。QC人员必须具备准确解释 EM 数据的知识和技能,并考虑培养时间、培养基成分以及双重培养方案影响微生物恢复的可能性等因素。
In cleanrooms, the choice of media plays a critical role in the recovery of contaminants
在洁净室中,培养基的选择对于污染物的回收起着至关重要的作用
By optimising EM practices for microbial contamination, cleanrooms can remain under control, ensuring that final products meet the highest standards of quality and safety. The insights gained from careful observation of growth patterns and colony morphology provide greater confidence in the recovery of viable bacteria, support investigations into root cause analyses, and guide the implementation of corrective actions to prevent future deviations.
通过优化微生物污染环境监测实践,洁净室可以得到控制,确保最终产品符合最高的质量和安全标准。通过仔细观察生长模式和菌落形态,可以更有信心地恢复活菌,支持调查根本原因分析,并指导实施纠正措施以防止将来出现偏差。
In industries where contamination can have significant consequences, these practices are essential for maintaining the integrity of cleanroom environments and ensuring the consistent delivery of safe, high-quality products.
在污染可能造成严重后果的行业中,这些实践对于维护洁净室环境的完整性以及确保持续交付安全、高质量的产品至关重要。
本文为网络转载,仅作分享交流,非商业用途,若涉侵权请联系删除。






